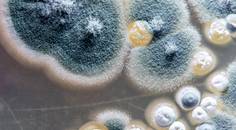
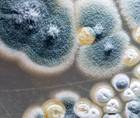

advertisement
Allergy, Asthma, and Immunology
49-64 of 240
- Medical NewsFungal Spores of the Mold Aspergillus Fumigatus Produce an Enzyme That Weakens the Immune System
phys.org
09/05/2024
medicalxpress.com
08/29/2024
nejm.org
08/27/2024- Medical NewsNasal Spray Flu Vaccine Candidate Based on UW–Madison Technology Shows Promise When Administered Alongside High Dose Annual Shot
news.wisc.edu
08/27/2024 - Medical NewsThe Antiviral Tecovirimat Is Safe but Did Not Improve Clade I Mpox Resolution in Democratic Republic of the Congo
nih.gov
08/27/2024
timeswv.com
08/27/2024
sciencedaily.com
08/27/2024
eurekalert.org
08/27/2024
theguardian.com
08/26/2024- Medical NewsResearchers Find Increased Mental Illnesses Incidence Following Severe COVID-19, Especially in Unvaccinated People
medicalxpress.com
08/22/2024
sciencedaily.com
08/19/2024
mynbc5.com
08/19/2024
phys.org
08/19/2024
nih.gov
08/16/2024
abdn.ac.uk
08/15/2024- Medical NewsClinical Trial Shows JAK Inhibitor Improves Multiple Autoimmune Conditions in Patients with Down Syndrome
medicalxpress.com
08/14/2024